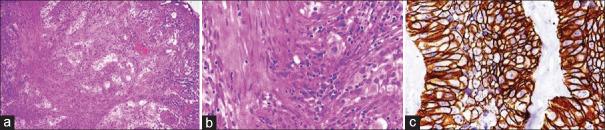
https://cdn.ncbi.nlm.nih.gov/pmc/blobs/91d2/10836454/7bb83a29869e/IJU-40-44-g001.jpg

人表皮生长因子受体2/neu在尿路上皮癌中的表达
Human epidermal growth factor receptor 2/neu expression in urothelial carcinomas.
作者信息
Soudamini Arsha Balakrishnan, Nalwa Aasma, Choudhary Gautam Ram, Bharti Jyotsna Naresh, Rao Meenakshi, Elhence Poonam Abhay, Pandey Himanshu, Goel Akhil Dhanesh
机构信息
Department of Pathology and Lab Medicine, All India Institute of Medical Sciences, Jodhpur, Rajasthan, India.
Department of Urology, All India Institute of Medical Sciences, Jodhpur, Rajasthan, India.
出版信息
Indian J Urol. 2024 Jan-Mar;40(1):44-48. doi: 10.4103/iju.iju_287_23. Epub 2023 Dec 29.
INTRODUCTION
Urothelial carcinomas of the bladder are more common in males, making them the sixth-most common cancer in men and the tenth-most common cancer overall, worldwide. Current guidelines do not recommend routine testing for human epidermal growth factor receptor (HER2/neu) expression on the biopsy specimens of patients with urothelial carcinoma. This study was aimed at determining the expression pattern of HER2/neu and its usefulness in muscle-invasive and nonmuscle-invasive urothelial carcinoma.
METHODS
HER2/neu expression was assessed in 89 specimens of urothelial cancer by immunohistochemistry (IHC), and equivocal cases were subjected to fluorescent in situ hybridization (FISH).
RESULTS
On IHC for HER2/neu, 17.9% (7/39) of the muscle-invasive bladder cancers (MIBCs) showed a 3+ expression, whereas 22% (11/50) of the non-muscle invasive cancers were positive with a score of 3+. A significant correlation between HER2/neu status and muscle invasion could not be established in the current study (P = 0.74, Fisher's exact test). Three cases of muscle-invasive (7.7%) and 2 cases (4%) among nonmuscle invasive cancers showed equivocal expression. All the cases with equivocal (2+) expression on IHC were subjected to FISH and none showed gene amplification on hybridization and were considered as negative.
CONCLUSION
Overexpression of HER-2/neu was seen in 17.9% of MIBCs and 22% of non-MIBCs. There are no norms for routine testing of HER2/neu expression in the biopsy specimens of urothelial carcinoma. There is an unmet need to establish guidelines for HER2/neu scoring, similar to that for breast and gastric cancers, to determine the proportion of positive cases and help in identification of those who may benefit from targeted therapies.
引言
膀胱尿路上皮癌在男性中更为常见,使其成为全球男性第六大常见癌症和总体第十大常见癌症。目前的指南不建议对尿路上皮癌患者的活检标本进行人表皮生长因子受体(HER2/neu)表达的常规检测。本研究旨在确定HER2/neu的表达模式及其在肌层浸润性和非肌层浸润性尿路上皮癌中的作用。
方法
通过免疫组织化学(IHC)对89例尿路上皮癌标本进行HER2/neu表达评估,对结果不明确的病例进行荧光原位杂交(FISH)检测。
结果
在HER2/neu的免疫组织化学检测中,17.9%(7/39)的肌层浸润性膀胱癌(MIBC)显示3+表达,而22%(11/50)的非肌层浸润性癌为3+阳性。在本研究中,无法确定HER2/neu状态与肌层浸润之间存在显著相关性(P = 0.74,Fisher精确检验)。3例肌层浸润性癌(7.7%)和2例非肌层浸润性癌(4%)显示表达不明确。所有免疫组织化学显示不明确(2+)表达的病例均进行了FISH检测,杂交时均未显示基因扩增,被视为阴性。
结论
17.9%的MIBC和22%的非MIBC中可见HER-2/neu过表达。尿路上皮癌活检标本中HER2/neu表达的常规检测尚无规范。迫切需要建立类似于乳腺癌和胃癌的HER2/neu评分指南,以确定阳性病例的比例,并有助于识别可能从靶向治疗中获益的患者。